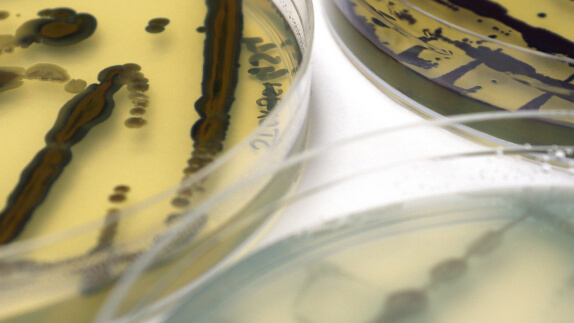
Close up photo of the biobased dyeing process

Biodiversity and fashion case studies
Examples of companies adopting practices for regenerative outcomes
Biodiversity and food case studies
Examples of companies adopting practices for regenerative outcomes
Biodiversity and plastic packaging case studies
Examples of companies adopting practices for regenerative outcomes
Biodiversity and built environment case studies
Examples of companies adopting practices for regenerative outcomes
Other sector case studies
Examples of companies adopting practices for regenerative outcomes

View all of our case studies
Explore our full library of case studies to discover more examples of the circular economy in action.